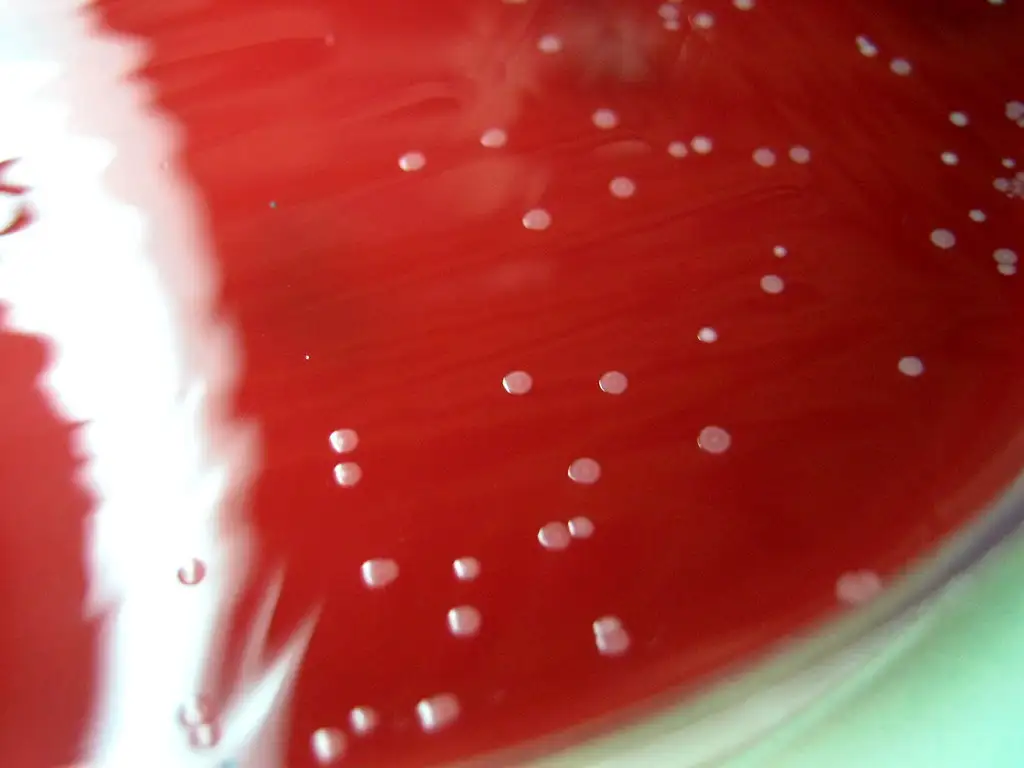
微生物世界的显微镜图像

一段跨越万年的血腥纠葛
在人类文明的漫长岁月中,有一种病毒始终如影随形。它比金字塔更古老,比文字更久远,在无声无息中夺取了数亿人的生命。它就是乙型肝炎病毒——地球上最成功的寄生虫之一。直到今天,全球仍有超过2.5亿人携带这种病毒,每年约有一百万人因此丧命。然而,人类真正认识这位古老敌人,不过是最近六十年的事。
古老骨骼中的黑暗秘密
2018年,一支国际研究团队在《自然》杂志上发表了一项震撼人心的发现。他们在欧亚大陆出土的4500年前人类骨骼中,成功提取到了乙型肝炎病毒的基因片段。这些古代病毒的DNA序列与现代乙型肝炎病毒惊人地相似,证明这种病原体已经在人类社会中潜伏了至少一万年。
更令人惊叹的是,韩国科学家在2016年从一具16世纪朝鲜王朝儿童的木乃伊中提取出了完整的乙型肝炎病毒基因组。这具保存完好的遗体提供了珍贵的古代病毒样本,让科学家得以追溯病毒的进化历程。研究发现,古代乙型肝炎病毒的基因结构与当今流行的毒株高度相似,这意味着病毒在数千年间几乎没有发生根本性改变。

这种惊人的稳定性揭示了乙型肝炎病毒的生存策略。与流感病毒不断变异以逃避人体免疫系统不同,乙型肝炎病毒选择了一条更阴险的道路:它建立了隐秘的潜伏库,在感染者体内建立永久据点,通过母婴传播将自身传递给下一代。这种策略如此成功,以至于病毒无需频繁变异就能维持种群的延续。
一位诺贝尔奖得主的意外发现
1963年,费城福克斯蔡斯癌症中心的巴鲁克·布隆伯格正在研究一种奇怪的现象。他发现来自不同地区的血液样本中,经常会出现一种神秘的蛋白质反应。这位训练有素的遗传学家最初以为自己在追踪某种遗传标记,却不知自己即将揭开医学史上最重要的发现之一。
布隆伯格注意到,一名澳大利亚原住民的血液样本中存在一种特殊的抗原,它能与一名血友病患者的血清发生反应。经过反复实验,他确认这是一种全新的蛋白质,并将其命名为"澳大利亚抗原"。当时没有人意识到,这个看似普通的发现将彻底改变人类对肝脏疾病的认知。

1967年,纽约大学的研究人员阿尔弗雷德·普林斯发现澳大利亚抗原与输血后肝炎密切相关。这个发现如同拼图中缺失的关键一块,瞬间揭示了抗原的真实身份:它是乙型肝炎病毒的外壳蛋白。布隆伯格因为这一开创性发现获得了1976年诺贝尔生理学或医学奖,而他的研究也为后来乙型肝炎疫苗的开发奠定了基础。
微观世界的隐形杀手
乙型肝炎病毒是已知最小的DNA病毒之一,直径仅约42纳米,相当于人类头发直径的千分之一。然而,这个微不足道的颗粒却拥有极其复杂的结构。病毒外层是由脂蛋白组成的包膜,内含病毒的遗传物质——一个部分双链的环状DNA分子,以及DNA聚合酶。这种独特的结构使得乙型肝炎病毒成为唯一一种使用逆转录机制进行复制的DNA病毒。
当病毒进入肝细胞后,它会释放出自己的基因组,并将其运输到细胞核中。在这里,病毒DNA被修复成完整的双链环状结构,形成所谓的"共价闭合环状DNA",简称cccDNA。这个看似微小的分子结构,却是乙型肝炎病毒最可怕的武器。

cccDNA极其稳定,能够在肝细胞核中存活数年甚至数十年。它像一个隐藏的指挥中心,不断产生新的病毒RNA和蛋白质,组装成新的病毒颗粒释放到血液中。更可怕的是,现有的抗病毒药物几乎无法彻底清除cccDNA。这就是为什么乙型肝炎感染如此难以治愈的根本原因。
免疫系统的致命误判
乙型肝炎病毒本身并不直接杀死肝细胞。真正造成肝脏损伤的,是人体自身的免疫系统。当免疫细胞发现被感染的肝细胞时,它们会发起猛烈攻击,试图消灭病毒。然而,这种攻击往往会导致大量肝细胞死亡,引发炎症反应。
在急性感染阶段,大多数成年人的免疫系统能够清除病毒。然而,约有5%的成年人会发展为慢性感染。在婴幼儿时期感染的人,发展为慢性感染的风险高达90%。这是因为发育中的免疫系统往往将病毒视为"自身"的一部分,不会发起有效攻击。

慢性乙型肝炎患者面临着多重威胁。持续的炎症会导致肝纤维化,进而发展为肝硬化。更可怕的是,乙型肝炎病毒是已知最强的致癌病毒之一。世界卫生组织估计,约25%的慢性感染者最终会死于肝硬化或肝细胞癌。这种癌症的预后极差,确诊后五年生存率不足20%。
一支疫苗拯救亿万生命
乙型肝炎疫苗的诞生堪称医学史上最传奇的故事之一。在布隆伯格发现澳大利亚抗原后不久,纽约血液中心的沃尔夫·兹姆尼斯和伊扎克·米尔曼意识到,从感染者血液中提纯的病毒表面抗原可以用来制造疫苗。然而,这种第一代疫苗存在一个根本性问题:它需要从感染者的血液中提取原料,既存在安全风险,又无法大规模生产。
真正的突破来自于莫里斯·希勒曼的天才创意。这位默克公司的疫苗学家提出了一种革命性的想法:使用基因工程技术,将乙型肝炎病毒的表面抗原基因插入酵母菌中,让微生物工厂大量生产疫苗蛋白。1986年,世界上第一种基因工程疫苗获得美国FDA批准上市,开创了疫苗生产的新纪元。
希勒曼的乙型肝炎疫苗被认为是史上最安全的疫苗之一,至今已接种超过十亿剂次。更重要的是,它是第一种被证明能够预防癌症的疫苗。在台湾,自1984年开始实施新生儿普遍接种后,儿童肝细胞癌的发病率下降了近70%。这一成就证明了通过疫苗接种消除病毒性癌症的可行性。
中国的乙肝战争
中国是世界上乙型肝炎负担最沉重的国家之一。在1992年全国血清流行病学调查中,超过10%的人口携带乙型肝炎病毒,约1.2亿人。这种高感染率与历史上的医疗实践密切相关:在一次性注射器普及之前,不安全的注射和输血导致了大量感染。此外,母婴传播也是重要的传播途径。
1992年,中国开始将乙型肝炎疫苗纳入计划免疫管理。2002年,乙肝疫苗被正式纳入国家免疫规划,新生儿免费接种。2005年,新生儿乙肝疫苗接种完全免费。这些政策的实施带来了惊人的效果:五岁以下儿童携带率从1992年的9.7%下降到2020年的0.3%,接近发达国家水平。
然而,挑战依然存在。中国仍有约7000万慢性乙型肝炎感染者,其中很多人并不知道自己已被感染。许多人只有在出现肝硬化或肝癌症状后才被确诊,错过了最佳治疗时机。提高筛查率、确保感染者获得及时治疗,成为当前防治工作的重点。
隐匿感染的黑暗角落
在乙型肝炎病毒的世界里,存在着一群特殊的感染者:他们的血液中检测不到表面抗原,却携带着病毒的遗传物质。这种被称为"隐匿性乙型肝炎感染"的现象,长期以来被医学界忽视。
隐匿性感染者的肝细胞中仍然存在cccDNA,但病毒的表面抗原基因发生了突变或沉默,导致常规检测无法发现。这些感染者虽然病毒载量较低,但仍可能传播病毒,也可能发展为肝脏疾病。更令人担忧的是,隐匿性感染者在接受免疫抑制治疗时,病毒可能重新激活,引发严重的肝脏炎症。
近年来,随着检测技术的进步,科学家们发现隐匿性感染比原先认为的更加普遍。一些研究估计,在曾经流行乙型肝炎的地区,隐匿性感染可能影响数百万人口。这一发现对输血安全、器官移植和临床诊断都提出了新的挑战。
从绝望到希望的治愈之路
直到最近,慢性乙型肝炎仍被视为一种无法治愈的疾病。现有的抗病毒药物——主要是核苷类似物和干扰素——只能抑制病毒复制,无法清除肝细胞中的cccDNA。患者需要终身服药,一旦停药,病毒往往会卷土重来。
然而,希望正在出现。2015年,科学家发现了一种可能彻底清除cccDNA的策略:利用CRISPR基因编辑技术,直接剪切病毒的DNA。在实验室培养的细胞中,这种方法成功消除了病毒的潜伏库。虽然距离临床应用还有很长的路要走,但这一发现证明彻底治愈乙型肝炎在理论上是可行的。

另一种有前景的策略是利用人体的免疫系统。科学家们正在开发新型免疫疗法,旨在"唤醒"患者体内沉睡的免疫细胞,使其能够识别并消灭被感染的肝细胞。一些早期的临床试验显示出了令人鼓舞的结果,部分患者在治疗后实现了功能性治愈——即使停药,病毒也不再复制。
世界卫生组织设定了雄心勃勃的目标:到2030年消除乙型肝炎作为公共卫生威胁。这意味着新发感染减少90%,死亡率降低65%。实现这一目标需要全球范围内的共同努力:普及疫苗接种、加强筛查诊断、确保感染者获得可负担的治疗。
被遗忘的医学耻辱
乙型肝炎的故事不仅仅是一部医学史,也是一部关于歧视与污名化的社会史。在中国、韩国等东亚国家,乙型肝炎感染者长期以来面临着严重的就业和教育歧视。许多用人单位拒绝录用携带者,一些高校甚至限制携带者报考某些专业。
这种歧视的根源在于对传播途径的误解。事实上,乙型肝炎主要通过血液、性和母婴传播,日常接触如握手、拥抱、共用餐具并不会传播病毒。然而,公众的恐惧往往超越了科学事实,导致感染者在就业、婚姻和社会生活中遭受不公正待遇。
2010年,中国政府明令禁止入学就业体检中检测乙型肝炎项目,这是消除歧视的重要一步。然而,改变根深蒂固的社会偏见需要时间。许多感染者仍然选择隐瞒自己的状况,宁愿独自承受疾病的重担,也不愿面对可能的社会排斥。
与死神赛跑的产房战场
对于乙型肝炎病毒而言,母婴传播是最有效的传播途径。在没有任何干预措施的情况下,e抗原阳性的母亲将病毒传给新生儿的几率高达90%。这些在出生时感染的婴儿几乎都会发展为慢性感染,成为病毒在人类社会中的长期储存库。
阻断母婴传播是消除乙型肝炎的关键战役。研究表明,在新生儿出生后12小时内注射乙型肝炎免疫球蛋白和第一剂疫苗,可以将母婴传播风险降低至5%以下。如果母亲在孕期接受抗病毒治疗,传播风险可以进一步降低。
在中国,母婴阻断项目已经覆盖全国。然而,在一些偏远地区,仍有一些婴儿因为错过了关键的12小时窗口期而感染病毒。每一个在产房里与时间赛跑的案例,都提醒着我们消除乙型肝炎的任务远未完成。
基因组中的远古印记
乙型肝炎病毒不仅在感染者的肝脏中留下痕迹,它甚至可能改写人类的基因组。科学家发现,在人类DNA中存在大量来自乙型肝炎病毒的基因片段,这些是古代感染留下的"化石"。在某些情况下,这些病毒基因被人类"驯服",甚至可能发挥有益的功能。
最著名的例子是同步素基因。这个基因最初来源于古代逆转录病毒,现在在哺乳动物的胎盘中发挥关键作用,帮助胚胎在子宫壁上着床。有科学家提出,古代乙型肝炎病毒的基因可能也以类似方式被人类基因组吸收,成为我们遗传遗产的一部分。
这些发现揭示了人类与病毒之间复杂而微妙的关系。我们不仅是病毒的受害者,在漫长的进化历程中,我们与这些微观邻居形成了一种共生关系。病毒塑造了我们的基因组,而我们的免疫系统也在不断适应这些古老的敌人。
未来的终结之战
乙型肝炎疫苗是人类对抗这种古老病毒最有力的武器。然而,即使在疫苗问世四十年后的今天,全球每年仍有约150万新发感染。这一方面是因为疫苗接种覆盖率仍然不足,另一方面是因为病毒已经建立了庞大的感染者储备库。
要真正终结乙型肝炎的威胁,需要三管齐下:首先是普及疫苗接种,阻断新发感染;其次是加强筛查,找出隐藏的感染者;最后是提供可负担的治疗,减少病毒传播和肝脏疾病死亡。每一个环节都至关重要,任何一个环节的缺失都可能导致病毒继续在人群中传播。
科学家们正在研发下一代疫苗。一些研究团队希望开发出能够治愈慢性感染的"治疗性疫苗",通过激发人体免疫系统来清除病毒。另一些团队则在探索更加简单易用的给药方式,如无需冷链储存的稳定疫苗,以便在资源有限地区推广接种。
结语:一场永不结束的战争
乙型肝炎病毒与人类的故事,是一部跨越万年的史诗。从青铜时代的猎人到现代都市的白领,从古老的木乃伊到基因测序实验室,这个微小的病毒始终伴随着我们。它见证了人类文明的兴衰,也在无形中塑造了我们的历史。
今天,我们比以往任何时候都更接近战胜这位古老的敌人。疫苗的普及让新一代人有机会免受感染,新型疗法为感染者带来了治愈的希望。然而,只要还有一人携带病毒,只要还有一处角落疫苗接种未能覆盖,乙型肝炎的威胁就依然存在。
这场战争不会有戏剧性的终结,没有最终的胜利宣言。它需要持续的投入、不懈的努力、科学的进步和全球的合作。每一剂接种的疫苗、每一个被确诊的感染者、每一次成功的治疗,都是向最终目标迈进的脚步。
在这场跨越千年的博弈中,人类第一次占据了上风。但我们永远不能忘记,这位沉默的对手从未真正放弃。它在等待我们松懈,等待我们的疫苗冷链断裂,等待我们的筛查系统失效。只要人类存在,这场战争就永远不会结束。
参考资料
-
Mühlemann B, et al. (2018). Ancient hepatitis B viruses from the Bronze Age to the Medieval period. Nature, 557(7705), 418-423.
-
World Health Organization. (2024). Global hepatitis report 2024: action for access in low- and middle-income countries.
-
Blumberg BS. (1977). Australia antigen and the biology of hepatitis B. Science, 197(4298), 17-25.
-
Hilleman MR. (2003). Critical overview and outlook: pathogenesis, prevention, and treatment of hepatitis and hepatocarcinoma caused by hepatitis B virus. Vaccine, 21(32), 4626-4649.
-
Seeger C, Mason WS. (2015). Molecular biology of hepatitis B virus infection. Virology, 479-480, 672-686.
-
Polaris Observatory Collaborators. (2018). Global prevalence, treatment, and prevention of hepatitis B virus infection in 2016: a modelling study. The Lancet Gastroenterology & Hepatology, 3(6), 383-403.
-
Chang MH, et al. (2016). Hepatitis B vaccination and the prevention of hepatocellular carcinoma. Journal of Clinical Oncology, 34(16), 1893-1901.
-
中国疾病预防控制中心. (2021). 中国病毒性肝炎防治规划.
-
Revill PA, et al. (2020). A global scientific strategy to cure hepatitis B. The Lancet Gastroenterology & Hepatology, 4(7), 545-558.
-
Raimondo G, et al. (2019). Update on the occult hepatitis B infection. Journal of Hepatology, 71(2), 394-408.